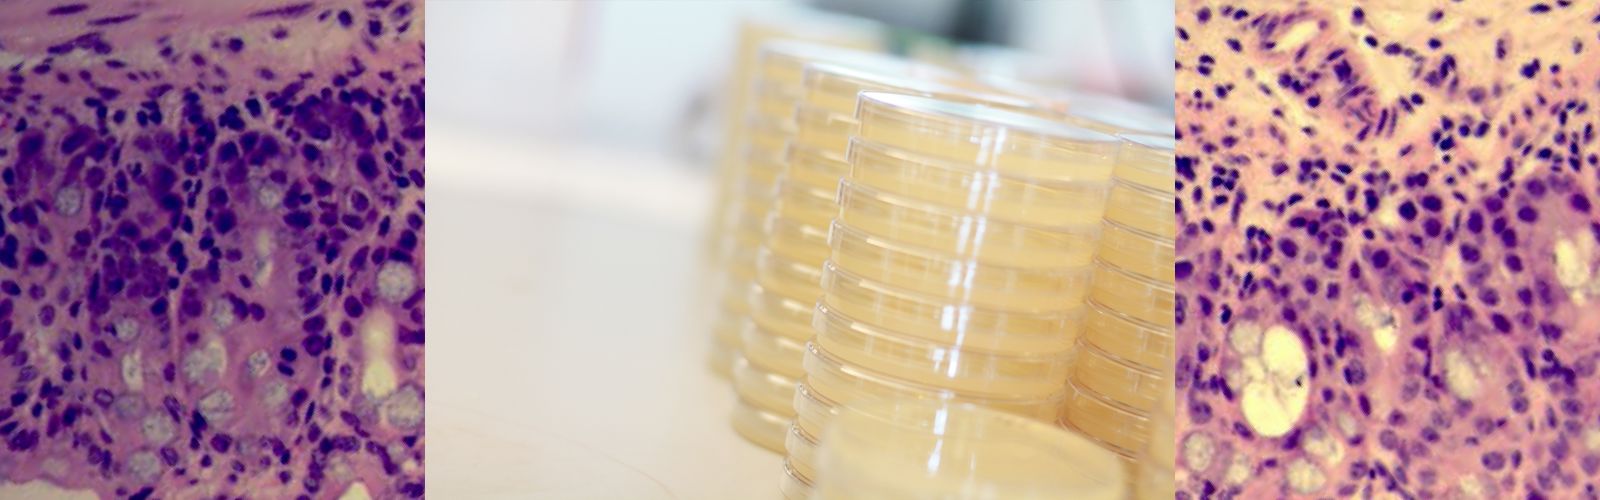
histo-petri-slide.png

Welcome to our lab, where we delve into the complex interactions between gut microbes and gastrointestinal (GI) physiology, especially the factors that maintain or disrupt this delicate ecological system. Our research explores how microbes and their metabolite products influence GI host physiology, particularly via intestinal multidrug efflux transporters and epithelial cell nuclear factors. By uncovering new ways that microbes interact with the GI tract and the innate immune system, we are paving the way for innovative therapies for treating GI disorders. Our ongoing efforts in drug discovery and development, including advancing a first-in-class molecule to Phase IIa clinical trials for ulcerative colitis (Adiso Therapeutics), reflect our commitment to translating our scientific discoveries into clinical solutions.